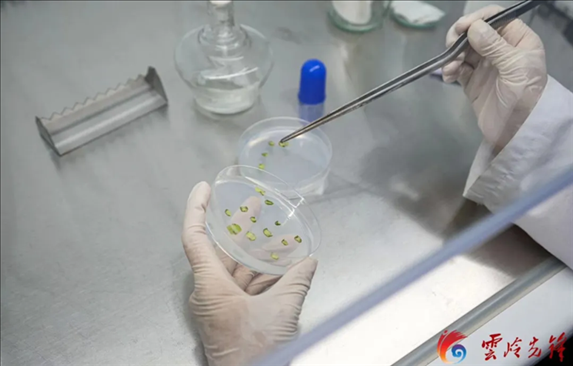
202405161532487078.png

云南省热带作物科学研究所(以下简称云南省热作所)于1953年成立,为省属公益一类农业科研事业单位,主要从事以橡胶树为主的热带生物资源的利用研究。
经过70余年的发展,云南省热作所已建成我国重要的热带农业研究中心。目前,在职人员290人,共有专业技术人员251人(含双肩挑6人),其中:高级职称88人,中级职称53人,博士、硕士155人,国务院特殊津贴专家1人、国家天然橡胶产业技术体系西双版纳综合试验站站长1人、国家木薯产业技术体系西双版纳(辣木)综合试验站站长1人、国家木薯产业技术体系辣木栽培模式岗位科学家1人、农业农村部杰出青年农业科学家1人、全国农业农村先进工作者1人、云南省政府特殊津贴专家1人、云南省有突出贡献优秀专业技术人才2人、云南省技术创新人才4人、云南省技术创新人才培养对象7人、云南省委联系专家1人、云南省现代农业橡胶产业技术体系首席科学家1人、云南省现代农业橡胶产业技术体系岗位科学家6人、云南省现代农业花卉产业技术体系西双版纳试验站站长1人、云南省兴滇英才4人、云南省科技副总3人、西双版纳州委联系专家3人、西双版纳州雨林英才9人、景洪市委联系专家2人。
云南省热带作物科学研究所在职人员290人,共有专业技术人员251人(含双肩挑6人),其中:高级职称88人,中级职称53人,博士、硕士155人,国务院特殊津贴专家1人、国家天然橡胶产业技术体系西双版纳综合试验站站长1人、国家木薯产业技术体系西双版纳(辣木)综合试验站站长1人、国家木薯产业技术体系辣木栽培模式岗位科学家1人、农业农村部杰出青年农业科学家1人、全国农业农村先进工作者1人、云南省政府特殊津贴专家1人、云南省有突出贡献优秀专业技术人才2人、云南省技术创新人才4人、云南省技术创新人才培养对象7人、云南省委联系专家1人、云南省现代农业橡胶产业技术体系首席科学家1人、云南省现代农业橡胶产业技术体系岗位科学家6人、云南省现代农业花卉产业技术体系西双版纳试验站站长1人、云南省兴滇英才4人、云南省科技副总3人、西双版纳州委联系专家3人、西双版纳州雨林英才9人、景洪市委联系专家2人。
云岭先锋网讯(记者 郝亚鑫 通讯员 白歆)近日,记者走进位于西双版纳州景洪市的云南省热带作物科学研究所,天然橡胶可持续利用研究重点实验室(以下简称:重点实验室)研究人员正在进行橡胶基因转到模式植物验证实验。

科研人员利用拉力检测器进行生胶性能检测。(郝亚鑫 摄)
2023年9月,由云南省热带作物科学研究所柳觐副所长牵头申报的“云南省天然橡胶可持续利用研究重点实验”获云南省科技厅批准建设。重点实验室将聚焦橡胶树抗寒高产品种选育及繁殖技术研究、生态经济型山地胶园建设研究、胶园养分管理与高效利用研究、胶园病虫害管理技术研究、安全高效采胶技术研究、高性能天然橡胶加工工艺技术研究等方面开展全面、系统的研发工作,着力解决当前云南省天然橡 胶产业中存在的多样化品种匮乏、胶园种植管理水平低下、采胶加工技术落后的现状,为云南天然橡胶产业高质量可持续发展提供有力的技术支撑。

科研人员利用硫化仪进行生胶性能检测。(郝亚鑫 摄)
云南省热带作物科学研究所柳觐副所长介绍,重点实验室将通过5-10年的建设,围绕开展天然橡胶产业共性技术研究、胶园提质增效关键技术集成示范、加强实验室人才培养的主要任务,力争成为省内一流、国内领先、在南亚东南亚地区有较强影响力的重点实验室和天然橡胶科技创新体系核心基地,推动云南省天然橡胶产业高质量可持续发展。

科研人员利用膜分离技术处理天然橡胶废水。(郝亚鑫 摄)

科研人员利用快速塑性仪做生胶塑性保持率测试。(郝亚鑫 摄)
科研人员进行橡胶基因转到模式植物验证实验。(郝亚鑫 摄)
来源:云岭先锋网
编辑:李白明
复核:李海泉